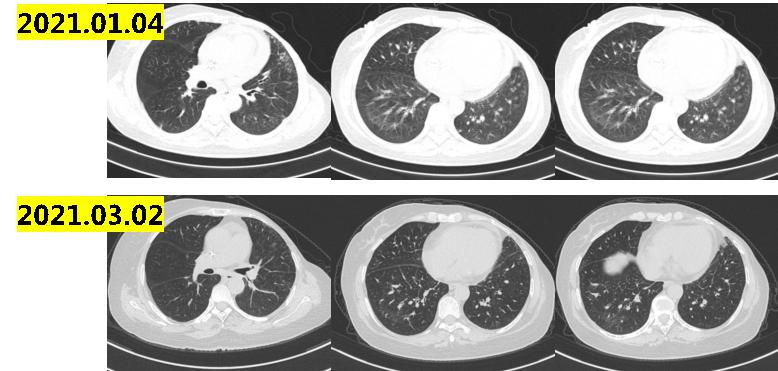
乳腺癌晚期没多少钱怎么治疗最佳,经济困难癌症晚期可以放弃治疗吗

编者按
乳腺癌是中国女性最常见的恶性肿瘤,多学科会诊的MDT治疗模式是提升乳腺癌患者治疗水平的重要模式。国家卫生健康委也强调,要积极推广多学科诊疗模式,开展多学科诊疗门诊及单病种多学科病例讨论和联合查房等制度,促进多学科诊疗团队的发展,提升肿瘤疾病的综合诊治水平和患者医疗服务舒适性。华中科技大学附属协和医院肿瘤中心乳腺肿瘤科胡婷医师在本文分享一例HR+转三阴晚期乳腺癌全程管理的病例,并邀请华中科技大学附属协和医院程晶教授进行点评。
专家简介

程晶 教授 主任医师 博士生导师 华中科技大学协和医院肿瘤中心乳腺肿瘤科主任

胡婷 教授 博士 主治医师 华中科技大学同济医学院附属协和医院肿瘤中心乳腺肿瘤科
病例摘要
基本信息:患者,女, 46岁,未绝经
主诉:因“左乳癌新辅助化疗后术后3周”于2018.03就诊我院
现病史:数十年前哺乳时发现左乳质硬肿块,偶伴疼痛,无红肿,未重视。2017.06开始出现皮肤破溃溢液,2017.10当地医院检查乳腺+腋窝淋巴结B超示:左乳占位性病变,左侧腋下低回声团。乳腺包块穿刺活检:乳腺浸润性导管癌(组织学分级:3级)。ER(+,70%,中等),PR(+,60%,强),HER2(1+),Ki67(LI:50%)。行6周期TAC新辅助化疗(化疗后乳腺肿块达PR,未达CR)。2018.02.05行“左乳癌改良根治术”:乳腺浸润性导管癌(组织学分级:3级),癌组织累及乳头及乳头皮肤,腋窝淋巴结(11/16)见有癌转移。ER(+,90%,中-强),PR(+,10%,中),HER-2(1+),Ki67(热区LI:10%),来我院行术后辅助放疗。
既往史及家族史:无特殊
体检阳性体征与重要阴性体征:左乳呈术后改变
主要辅助检查:
肿瘤标志物:CEA,CA 153(-)
胸部CT、肝脏B超未见异常
2018.03骨ECT:胸骨下段骨质代谢异常活跃灶,骨转移可能性大
2018.03胸骨CT:胸骨体下段局部密度增高
诊断:左乳浸润性导管癌 pT4N3M1(骨) LuminaB型
首次MDT讨论
讨论时间:2018.03.07
讨论科室:肿瘤中心、甲乳外科、影像科、病理科
讨论意见:患者确诊为:左乳浸润性导管癌 pT4N3M1(骨) LuminaB型。局部治疗上建议完成胸壁+锁上+内乳淋巴结引流区放疗。全身治疗方面根据2018版CSCO指南:因为药物可及性原因AI+CDK4/6*制剂抑**+OFS治疗为二级推荐,一级推荐是氟维司群+OFS或AI+OFS。临床试验数据显示氟维司群优于AI,然而进口氟维司群价格昂贵尚未进入医保,患者无法负担;考虑到患者T分期和N分期都很晚,属于高危患者,建议术后行6周期卡培他滨方案化疗,再转AI内分泌治疗。
执行情况及治疗结局:
2018.03.14完成左胸壁+锁骨上+内乳区淋巴结引流区 CTV 50GY/25F,随后行OFS+卡培他滨+唑来磷酸6周期,后行OFS+来曲唑+唑来磷酸治疗2年,患者当地复查疗效SD。
2020.5.11复查PET-CT:双肺及胸膜下多发结节,部分代谢稍高,考虑多为转移性病变;胸骨骨质代谢轻度增高(图1-1)。全身骨ECT:胸骨下段骨质代谢异常活跃,与前次比较变化不明显。

图1-1
第二次MDT讨论
讨论时间:2020.05
讨论科室:肿瘤中心、甲乳外科、影像科、病理科
讨论意见:患者OFS+来曲唑+唑来磷酸治疗2年出现疾病进展(双肺转移),根据2020年CSCO指南:对于HR+晚期乳腺癌没有内脏危象这部分患者,一级推荐是氟维司群+ CDK4/6*制剂抑**,二级推荐氟维司群。然而进口CDK4/6*制剂抑**和氟维司群均未进入医保,价格昂贵,患者无法负担,只能退而求其次选择白蛋白紫杉醇化疗。
执行情况及治疗结局:
2020.05~2020.09行6周期白蛋白紫杉醇,期间疗效评价为SD(图1-2)。2020年8月国产氟维司群上市,为减轻患者的负担,国产氟维司群上市之后给予中国患者相应的援助项目。在慈善赠药的帮助下,2020.09~2021.06患者接受氟维司群维持治疗9个月,于当地定期复查疗效评价为SD。
2021.6.10复查肺部ct示:双肺散在实性结节,最大10×8mm,部分病灶较前稍增大;纵隔及肺门淋巴结增大,最大直径13mm(图1-3),考虑病情进展。

图1-2

图1-3
第三次MDT讨论
讨论时间:2021.06
讨论科室:肿瘤中心、甲乳外科、影像科、病理科
讨论意见:患者转移病灶瘤负荷低,双肺和纵隔转移数目小于5个,最大直径1.3cm,无内脏危象,建议CDK4/6*制剂抑**联合内分泌治疗。然而进口CDK4/6*制剂抑**患者仍因经济原因无法负担。患者情况符合国产CDK4/6*制剂抑**临床试验入组标准,建议入组:XZP-3287(吡罗西尼)治疗中国晚期恶性实体瘤受试者的多中心、开放性Ⅰ/Ⅱ期临床研究。
执行情况及治疗结局:
2021.06-2021.09入组:XZP-3287(吡罗西尼)治疗中国晚期恶性实体瘤受试者的多中心、开放性Ⅰ/Ⅱ期临床研究,2021.09初患者开始出现胸闷气喘,2021.09.17肺部CT示:双肺下叶炎性病变,双肺下叶小叶间隔增厚,考虑间质性病变;双肺散在结节影,部分同前相仿,部分较前新发,考虑转移可能;心包积液,较前增多。示双肺及叶间裂胸膜处多发小结节,较前新发,考虑病情进展(图1-4)。

图1-4
第四次MDT讨论
讨论时间:2021.09
讨论科室:肿瘤中心、甲乳外科、影像科、病理科
讨论意见:患者CDK4/6*制剂抑**治疗后出现间质性肺炎改变,建议行抗生素+激素治疗。诊断为乳腺癌综合治疗后进展(双肺、纵隔、心包积液),建议行心包积液穿刺引流+沉渣包埋明确病理和分子分型,再决定进一步治疗方案。
执行情况及治疗结局:
心包穿刺引流:查见癌细胞,提示乳腺来源可能性大。ER(-),PR(-),HER2(0),Ki67(LI:20%)。备注:细胞沉渣制成蜡块1个,镜下查见癌细胞数量约300个,所占比例<1%。提示患者已经由HR+转成三阴型乳腺癌。患者给予抗生素、激素治疗后患者症状好转,行长春瑞滨口服周方案化疗5周。
2021.11患者再次出院胸闷气喘,2021.11.05复查肺部CT示:双肺新增斑片影、小叶间隔增厚,考虑间质性炎症或感染性病变,较前新增;左肺下叶支扩伴感染,双肺散在结节影,左肺上叶新增结节,考虑转移可能;少量心包积液(图1-5)。

图1-5
第五次MDT讨论
讨论时间:2021.11
讨论科室:肿瘤中心、甲乳外科、影像科、病理科
讨论意见:患者长春瑞滨治疗后再次出现间质性肺炎改变,肺部CT提示病情进展,建议行抗生素+激素治疗。诊断为左乳癌综合治疗后进展(双肺、胸膜、纵隔LN、心包积液)三阴型,患者既往使用过EC-T、白蛋白紫杉醇、卡培他滨和长春瑞滨化疗方案,根据2021CSCO指南:建议患者行艾利布林或者UTD1方案化疗。艾利布林属于进口药物,价格昂贵,UTD1属于国产原研药物,但有买2赠终身的慈善政策。
执行情况及治疗结局:
行抗生素激素治疗后患者症状明显缓解,影像学提示间质性改变较前明显改善(图1-6),2021.11.23-2022.04行UTD1化疗6周期,疗效评价PR(图1-7,1-8)。

图1-6
图1-7

图1-8
指导专家点评
程晶教授:
乳腺癌骨转移患者中最常见的亚型是HR阳性和HER2阴性乳腺癌,约占64.4%。对于初诊的Ⅳ期乳腺癌患者切除原发病灶是否能够获益尚有争论,以延长生存时间为目的的手术需要谨慎个体化选择。在转移负荷较小,系统治疗有效的情况下,局部手术有获益趋势的部分患者或因溃疡出血等可以考虑姑息性手术。该患者初诊就是cT4N+,术前应该完善骨扫描检查。同时乳腺癌新辅助化疗,及辅助化疗后要密切关注骨髓抑制,2021年《中国临床肿瘤学会(CSCO)肿瘤放化疗相关中性粒细胞减少症规范化管理指南(2021)》为规范化管理肿瘤治疗相关中性粒细胞减少症提供重要依据。
患者初诊即为乳腺癌晚期,HR+型转为三阴型,经济困难,通过积极合适的个体化治疗后取得良好的治疗效果,延长了患者的生存期。近几年,许多癌症的治疗取得了巨大的进展,靶向药和新型化疗药物治疗的兴起让许多患者看到了长期生存、甚至治愈的希望。伴随医疗进步而来的,还有触不可及的天价费用。乳腺癌具有复杂难治、需长期用药的特点,患者普遍面临沉重的费用负担。为了降低患者费用压力,在国家医保部门和民族医药企业的努力下,近年来有一批批乳腺癌新药国产化、降价进医保或者企业开展慈善赠药,让乳腺癌患者不再“闻之色变”。而对于患者而言,在新药问世、药品降价的背景下,意味着得到重生的机会!